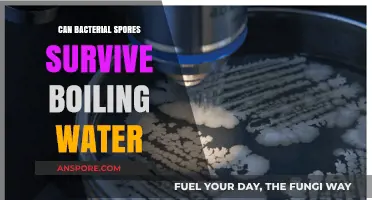
Can Bacterial Spores Survive Boiling Water? Uncovering the Truth

Bacterial spores are highly resistant structures produced by certain bacteria to survive harsh environmental conditions, making them particularly challenging to eliminate. One of the most effective methods for destroying bacterial spores is sterilization using an autoclave, a device that employs high-pressure steam at elevated temperatures. Autoclaves typically operate at temperatures between 121°C and 134°C, which are sufficient to denature the proteins and disrupt the cellular structures of bacterial spores, rendering them non-viable. However, the effectiveness of autoclave sterilization depends on factors such as the duration of exposure, the type of spore, and the proper functioning of the equipment. While autoclaving is widely regarded as a reliable method for spore destruction, certain highly resistant spores, such as those of *Clostridium botulinum* and *Bacillus anthracis*, may require extended cycles or higher temperatures to ensure complete inactivation. Understanding the capabilities and limitations of autoclave sterilization is crucial for applications in microbiology, healthcare, and food safety, where the elimination of bacterial spores is essential to prevent contamination and infection.
| Characteristics | Values |
|---|---|
| Effectiveness | Yes, bacterial spores can be destroyed by sterilization in an autoclave. |
| Required Conditions | High temperature (typically 121°C or 134°C), high pressure (15-20 psi), and sufficient exposure time (usually 15-30 minutes for 121°C, or 3-5 minutes for 134°C). |
| Mechanism | Moist heat coagulates spore proteins, disrupts cell membranes, and denatures enzymes, leading to spore inactivation. |
| Spore Resistance | Bacterial spores (e.g., Clostridium botulinum, Bacillus anthracis) are highly resistant but not invincible to autoclaving. |
| Cycle Types | Gravity displacement (121°C, 15-30 min) or pre-vacuum (134°C, 3-5 min) cycles are commonly used for spore destruction. |
| Validation | Spores of Geobacillus stearothermophilus are often used as biological indicators to validate autoclave effectiveness. |
| Limitations | Improper loading, insufficient time, or inadequate temperature/pressure can result in spore survival. |
| Applications | Widely used in laboratories, medical facilities, and industries for sterilizing media, instruments, and waste. |
| Alternative Methods | If autoclaving fails, chemical sterilants (e.g., hydrogen peroxide, peracetic acid) or dry heat sterilization may be used. |
| Safety | Autoclaving is considered the gold standard for spore destruction due to its reliability and safety when performed correctly. |
Explore related products
What You'll Learn

Autoclave Temperature and Time Requirements for Spores
Bacterial spores, renowned for their resilience, pose a significant challenge in sterilization processes. Autoclaves, utilizing steam under pressure, are a cornerstone of spore destruction, but success hinges on precise temperature and time parameters.
Simply put, insufficient exposure to heat will leave spores unscathed, while excessive conditions can damage materials.
The gold standard for spore eradication in an autoclave is a temperature of 121°C (250°F) maintained for a minimum of 15 minutes at 15 psi (pounds per square inch) pressure. This cycle, known as the "gravity displacement" method, is effective for most laboratory and medical applications. However, for materials that are heat-sensitive or prone to moisture damage, a "pre-vacuum" cycle is recommended. This method removes air from the chamber before introducing steam, allowing for faster heating and more efficient penetration of steam, reducing the required time to 4 minutes at 134°C (273°F).
It's crucial to note that these times are based on the assumption that the load is properly prepared – items should be loosely packed to allow steam penetration, and liquids should be in containers that can withstand the pressure.
While the standard cycles are effective for most spores, some highly resistant species, such as those from the genus *Bacillus*, may require more stringent conditions. In such cases, extending the sterilization time to 30-45 minutes at 121°C or using a higher temperature of 134°C for 7 minutes can be necessary. It's important to consult manufacturer guidelines for specific autoclave models and to validate the sterilization process regularly to ensure efficacy.
Overlooking these details can lead to false sterilization, potentially compromising safety in laboratory and medical settings.
Are Spores Single-Celled? Unveiling the Microscopic Truth
You may want to see also

Effectiveness of Steam Sterilization on Bacterial Spores
Bacterial spores are among the most resilient biological entities, capable of withstanding extreme conditions that would destroy their vegetative counterparts. Steam sterilization, commonly performed in an autoclave, is a widely accepted method for eliminating microorganisms, but its effectiveness against bacterial spores requires specific conditions. Autoclaves operate by exposing materials to saturated steam at high temperatures, typically 121°C (250°F) for 15–30 minutes at 15 psi, which denatures proteins and disrupts cellular structures. However, spores, particularly those of *Clostridium botulinum* and *Bacillus* species, possess a thick, protective coat and low water content, making them significantly more resistant to heat. To ensure spore destruction, the autoclave cycle must achieve a minimum of 121°C for 30 minutes, with proper loading and ventilation to allow steam penetration.
The effectiveness of steam sterilization on bacterial spores hinges on several critical factors. First, the autoclave must reach and maintain the required temperature and pressure uniformly throughout the chamber. Inadequate heating or improper loading can create cold spots, allowing spores to survive. Second, the material being sterilized must be free of air pockets, as steam penetration is essential for spore inactivation. Wrapping items in porous packaging or using autoclave bags can facilitate steam contact. Lastly, the type and concentration of spores influence their susceptibility; for example, *Geobacillus stearothermophilus* spores are commonly used as biological indicators due to their high resistance, requiring more stringent conditions for inactivation.
Practical tips for maximizing autoclave effectiveness include preheating materials to reduce cycle time, ensuring proper ventilation by using loose-fitting lids or autoclave tape, and avoiding overloading the chamber. For laboratories and medical facilities, routine monitoring with biological indicators is essential to validate sterilization efficacy. These indicators contain spore strips that change color if sterilization fails, providing a reliable test of the autoclave’s performance. Additionally, chemical indicators, such as autoclave tape or strips, can confirm exposure to high temperatures but do not guarantee spore destruction. Combining both methods ensures comprehensive validation.
Despite its robustness, steam sterilization is not infallible. Spores of certain bacteria, such as *Bacillus anthracis*, may require extended cycles or higher temperatures (e.g., 132°C for 10 minutes) for complete inactivation. In critical applications, such as surgical instrument sterilization, double-wrapping items and extending cycle times can provide an added safety margin. For heat-sensitive materials, alternative methods like dry heat sterilization or chemical disinfectants may be necessary, though these are generally less effective against spores. Understanding the limitations and optimizing autoclave use ensures reliable spore destruction in most scenarios.
In conclusion, steam sterilization in an autoclave is a highly effective method for destroying bacterial spores when executed correctly. By adhering to specific temperature, pressure, and time parameters, and by following best practices for loading and monitoring, users can achieve consistent results. However, the resilience of spores demands vigilance and validation to prevent survival. Whether in a laboratory, healthcare setting, or industrial application, mastering autoclave techniques is crucial for ensuring safety and sterility.
Spores vs. Pollen: Unraveling the Differences in Plant Reproduction
You may want to see also

Resistance Mechanisms of Spores in Autoclaves
Bacterial spores, particularly those of *Bacillus* and *Clostridium* species, are renowned for their resilience, surviving extreme conditions that would destroy vegetative cells. Autoclaves, which use steam under pressure (typically 121°C for 15–30 minutes at 15 psi), are a gold standard for sterilization, yet spores can still resist this process under certain conditions. Their resistance stems from a combination of structural, chemical, and physiological mechanisms that shield their genetic material and metabolic machinery. Understanding these mechanisms is critical for optimizing sterilization protocols and ensuring complete spore inactivation.
One key resistance mechanism lies in the spore’s multilayered structure. The outer coat, composed of keratin-like proteins, acts as a physical barrier against heat and chemicals. Beneath this lies the cortex, rich in peptidoglycan, which maintains spore dehydration—a critical state for survival. The core, containing the spore’s DNA, is protected by dipicolinic acid (DPA), a calcium-chelating molecule that binds water and stabilizes DNA against heat-induced damage. During autoclaving, DPA must be released, and the spore must rehydrate to allow heat penetration, a process that requires time and sufficient moisture. Inadequate exposure time or improper loading of the autoclave (e.g., overloading or insufficient steam penetration) can leave spores in a partially hydrated state, enabling survival.
Another resistance factor is the spore’s ability to repair DNA damage post-exposure. Spores possess small, acid-soluble proteins (SASPs) that bind and protect DNA from heat and desiccation. After autoclaving, if spores are not completely destroyed, they may germinate and activate DNA repair enzymes, restoring viability. This underscores the importance of using validated sterilization cycles and avoiding shortcuts, such as reducing cycle times or temperatures, which may leave spores in a sublethal injury state.
Practical tips for overcoming spore resistance include ensuring proper autoclave loading to allow steam penetration, using sterilization indicators (e.g., biological indicators containing *Geobacillus stearothermophilus* spores), and verifying cycle parameters (temperature, pressure, and time). For high-risk materials or critical applications, extending the autoclave cycle to 134°C for 3–5 minutes or using a double-cycle process can enhance spore inactivation. Regular maintenance of autoclave equipment and staff training on correct usage are equally vital to minimize resistance-related failures.
In summary, while autoclaves are highly effective, spore resistance mechanisms demand precision and adherence to protocols. By understanding the structural and physiological defenses of spores, laboratories and industries can implement strategies to ensure complete sterilization, safeguarding against contamination and infection.
Are Shrooms Spores Legal? Exploring the Legal Landscape of Psilocybin
You may want to see also
Explore related products

Validation of Autoclave Cycles for Spore Destruction
Bacterial spores, renowned for their resilience, pose a significant challenge in sterilization processes. Autoclaves, utilizing steam under pressure, are widely employed to destroy these spores, but effectiveness hinges on precise cycle validation. This validation ensures that every spore within a load is exposed to lethal conditions, typically defined as 121°C for 15-30 minutes at 15 psi (pounds per square inch). However, these parameters are not universal; they must be tailored to the specific autoclave, load type, and spore species.
Validation Protocols: A Step-by-Step Guide
Validation begins with selecting a suitable biological indicator (BI), typically containing *Geobacillus stearothermophilus* spores, known for their resistance to steam sterilization. These BIs are strategically placed within the autoclave chamber, simulating the most challenging locations for steam penetration, such as the center of a densely packed load. After the cycle, BIs are incubated at 55-60°C for 24-48 hours. Absence of growth confirms spore destruction, while growth indicates cycle failure.
Critical Factors Influencing Validation
Several factors can compromise autoclave efficacy. Inadequate steam penetration due to overloading, improper packaging, or insufficient cycle time are common culprits. Temperature differentials within the chamber, often caused by poor air removal, can leave cold spots where spores survive. Additionally, the age and condition of the autoclave, including worn gaskets or malfunctioning pressure gauges, can significantly impact performance. Regular maintenance and calibration are essential to mitigate these risks.
Comparative Analysis: Physical vs. Biological Monitoring
While physical monitoring (temperature and pressure recordings) provides valuable data, it does not guarantee spore destruction. Biological indicators offer a direct measure of lethality, serving as the gold standard for validation. Combining both methods enhances confidence in autoclave performance. For instance, a cycle may reach 121°C but fail to maintain it uniformly, leading to spore survival. Biological indicators would detect this failure, whereas physical monitoring alone might not.
Practical Tips for Successful Validation
To ensure robust validation, follow these guidelines: use fresh BIs from reputable suppliers, rotate their placement within the autoclave to account for variability, and document all results meticulously. For critical applications, such as medical device sterilization, validate cycles quarterly or after any equipment modification. In research settings, annual validation may suffice, but always after maintenance or suspected malfunctions. Adhering to these practices not only ensures compliance with regulatory standards but also safeguards against contamination risks.
Are Spore Syringes Legal in Florida? Understanding the Current Laws
You may want to see also

Comparing Autoclave Methods for Sporicidal Efficiency
Bacterial spores, renowned for their resilience, pose a significant challenge in sterilization processes. Autoclaves, widely used for their efficacy, employ various methods to achieve sporicidal efficiency. Among these, the most common are gravity displacement, prevacuum, and high-velocity steam methods. Each method varies in its approach to steam penetration and air removal, directly impacting its ability to destroy spores. Understanding these differences is crucial for selecting the appropriate autoclave method for specific sterilization needs.
Gravity Displacement Autoclaves: A Traditional Approach
Gravity displacement autoclaves operate by allowing steam to enter the chamber, displacing air through a drain at the bottom. This method is effective for sterilizing liquids and non-porous materials but struggles with porous items and those in tightly packed loads. The slow air removal process can lead to cold spots, reducing sporicidal efficiency. For example, *Clostridium sporogenes* spores, commonly used as biological indicators, may survive if the steam fails to penetrate deeply enough. To enhance effectiveness, users should avoid overloading the chamber and ensure proper arrangement of items to facilitate steam flow.
Prevacuum Autoclaves: Enhancing Penetration
Prevacuum autoclaves address the limitations of gravity displacement by using a vacuum pump to remove air before introducing steam. This method ensures rapid and uniform steam penetration, even in porous materials and complex loads. The combination of high temperature (121°C to 134°C) and pressure (15-30 psi) effectively destroys bacterial spores within 3 to 15 minutes, depending on the cycle. For instance, a 134°C prevacuum cycle for 3 minutes is commonly used in medical settings to sterilize surgical instruments. This method is ideal for heat-sensitive materials and large, dense loads, making it a preferred choice in healthcare and research environments.
High-Velocity Steam Autoclaves: Speed and Efficiency
High-velocity steam autoclaves utilize a rapid steam flow to remove air and achieve sterilization in record time. This method is particularly effective for destroying spores in large volumes of liquids or materials with high air content. For example, a cycle at 135°C for 90 seconds can achieve sporicidal efficiency comparable to longer cycles in traditional autoclaves. However, this method requires specialized equipment and precise control to avoid damaging heat-sensitive materials. It is often used in pharmaceutical manufacturing, where speed and consistency are critical.
Practical Considerations and Takeaways
When comparing autoclave methods for sporicidal efficiency, the choice depends on the load type, material sensitivity, and required cycle time. Gravity displacement is cost-effective but limited in scope, while prevacuum and high-velocity steam methods offer superior penetration and speed, albeit at a higher cost. For optimal results, users should validate sterilization cycles using biological indicators, such as *Geobacillus stearothermophilus* spores, which are highly resistant and serve as a reliable test for sporicidal efficacy. By matching the autoclave method to the specific application, users can ensure thorough sterilization while minimizing energy consumption and equipment wear.
How Wind Disperses Spores: Exploring Nature's Aerial Seed Scattering
You may want to see also
Frequently asked questions
Yes, bacterial spores can be effectively destroyed by sterilization in an autoclave when the correct temperature, pressure, and time parameters are used.
Bacterial spores are typically destroyed at a temperature of 121°C (250°F) and a pressure of 15 psi for at least 15-30 minutes, depending on the autoclave’s cycle.
No, some bacterial spores, such as those of *Clostridium botulinum* and *Bacillus anthracis*, are more resistant and may require longer exposure times or higher temperatures to ensure complete destruction.
Yes, if the autoclave cycle is not completed properly (e.g., insufficient time, temperature, or pressure), bacterial spores may survive. Proper monitoring and validation of the autoclave process are essential to ensure sterilization.